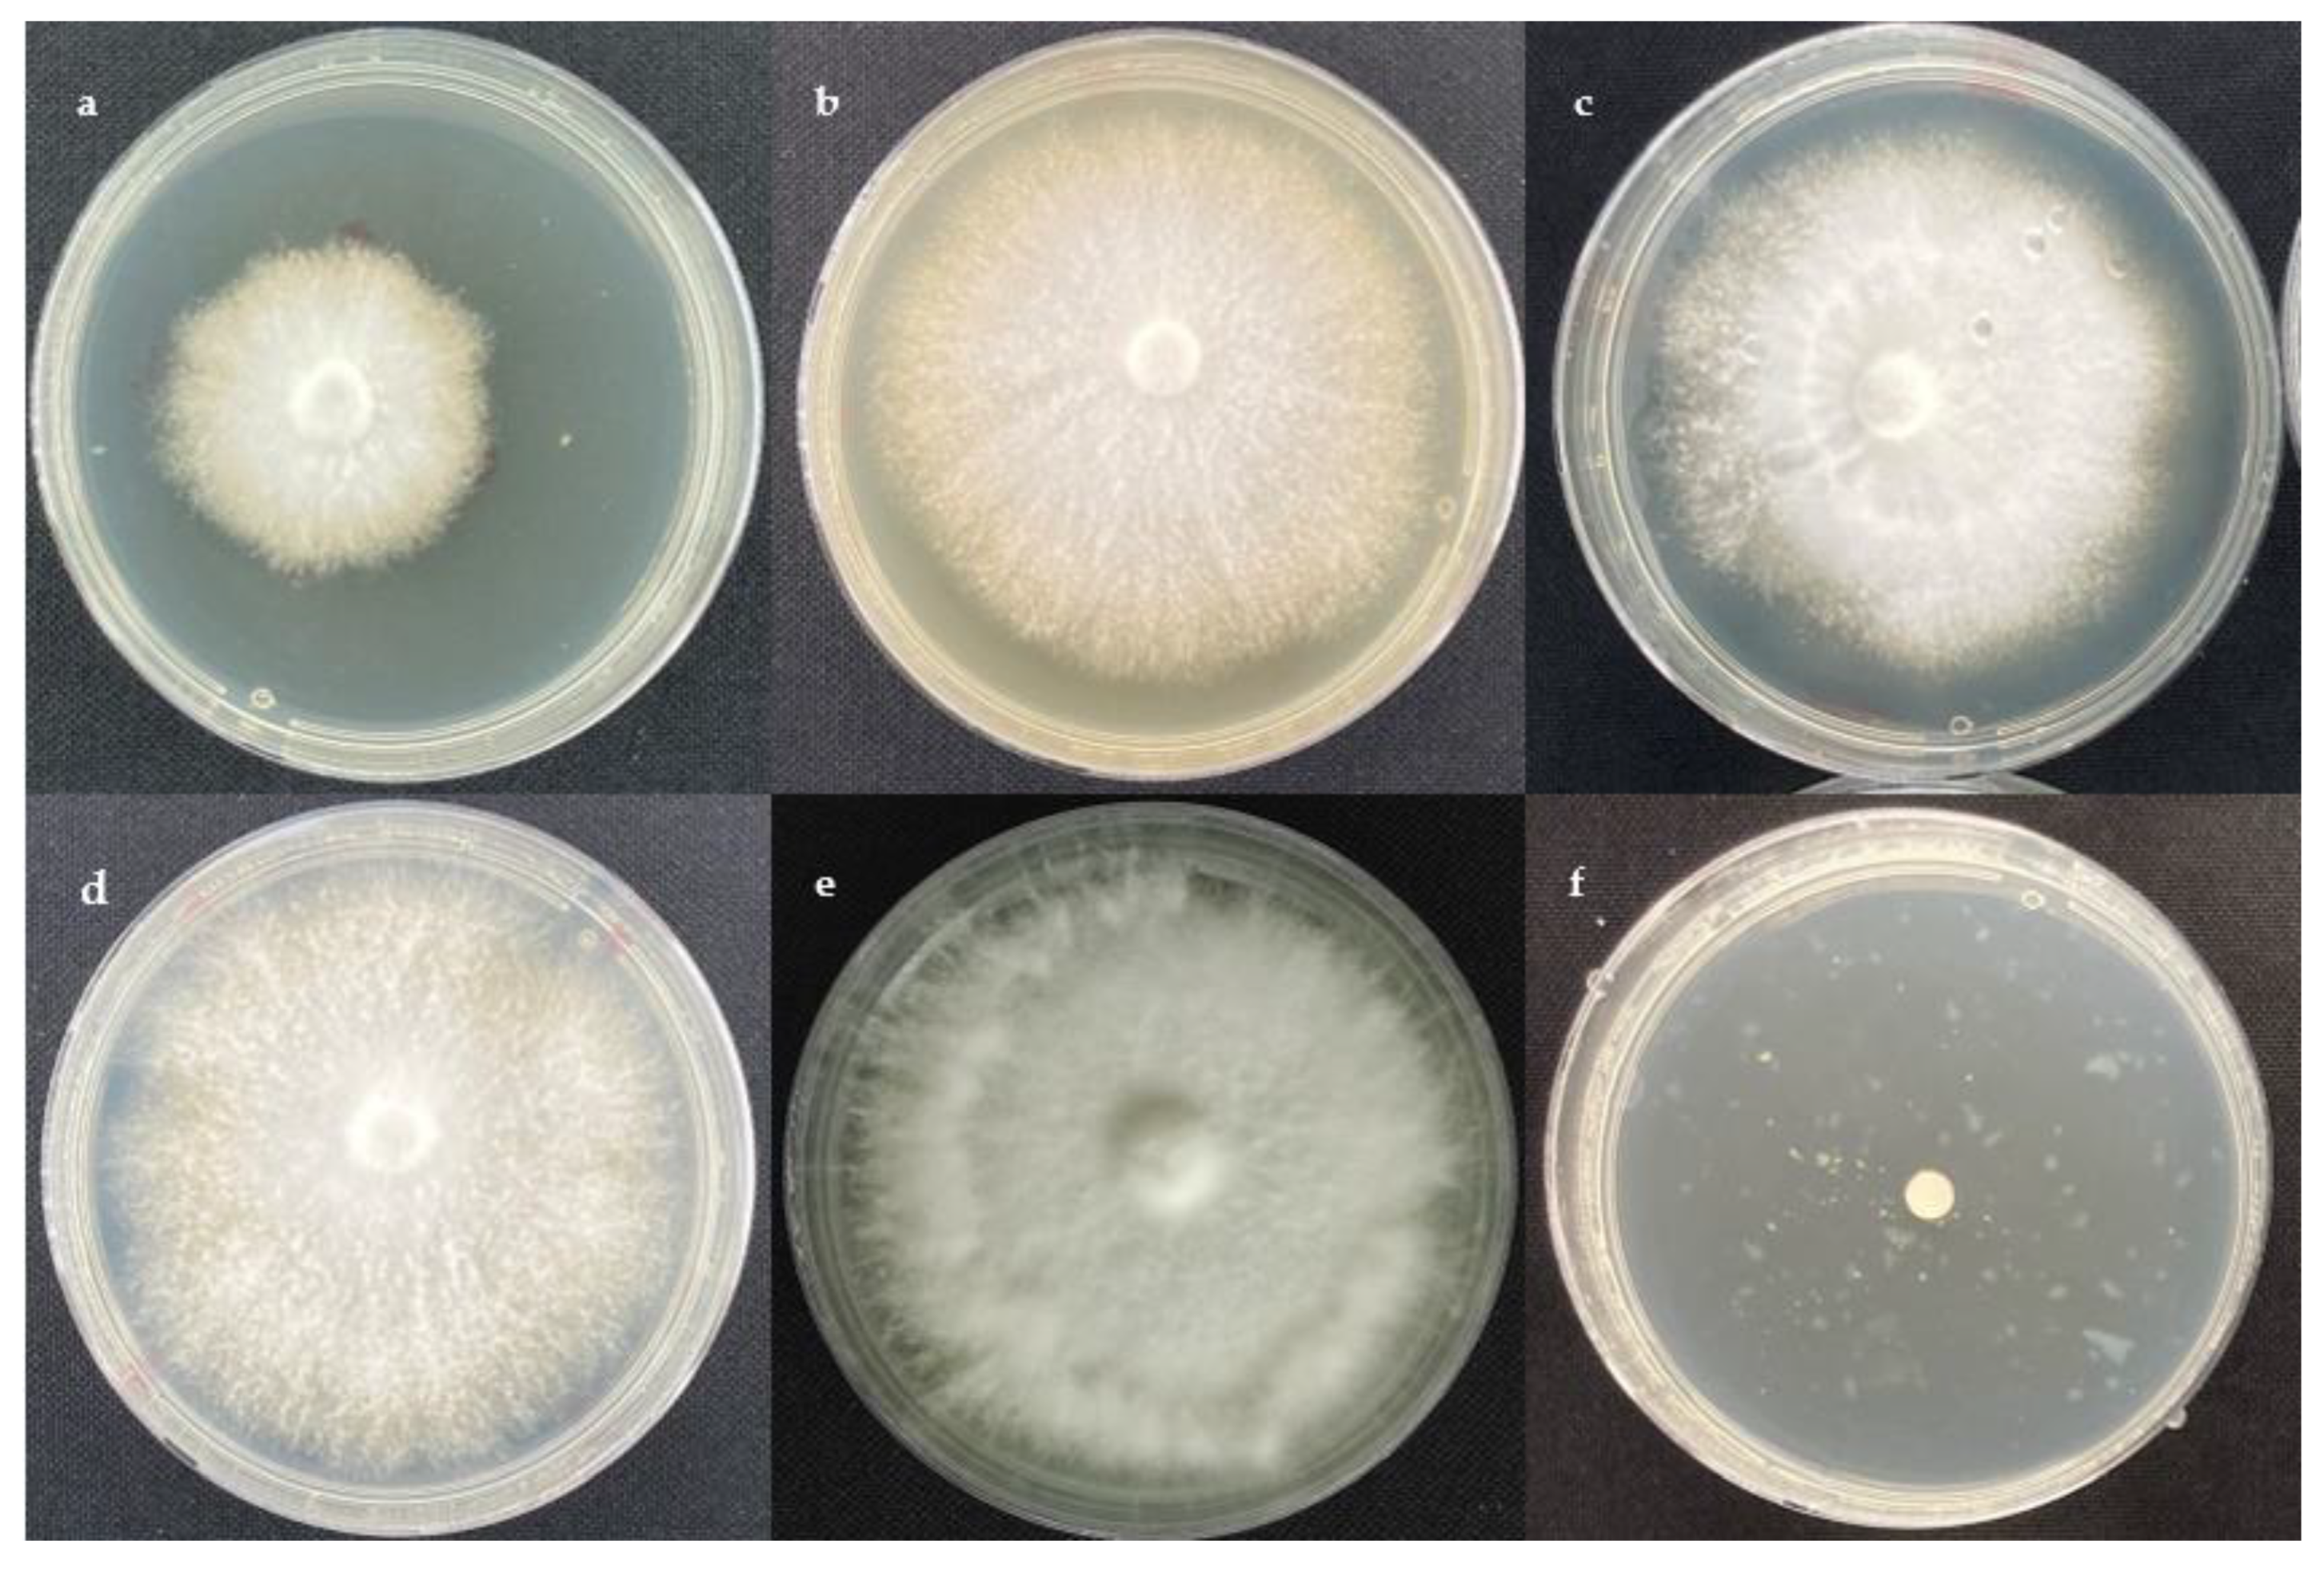
Molecules 28 03208 g001
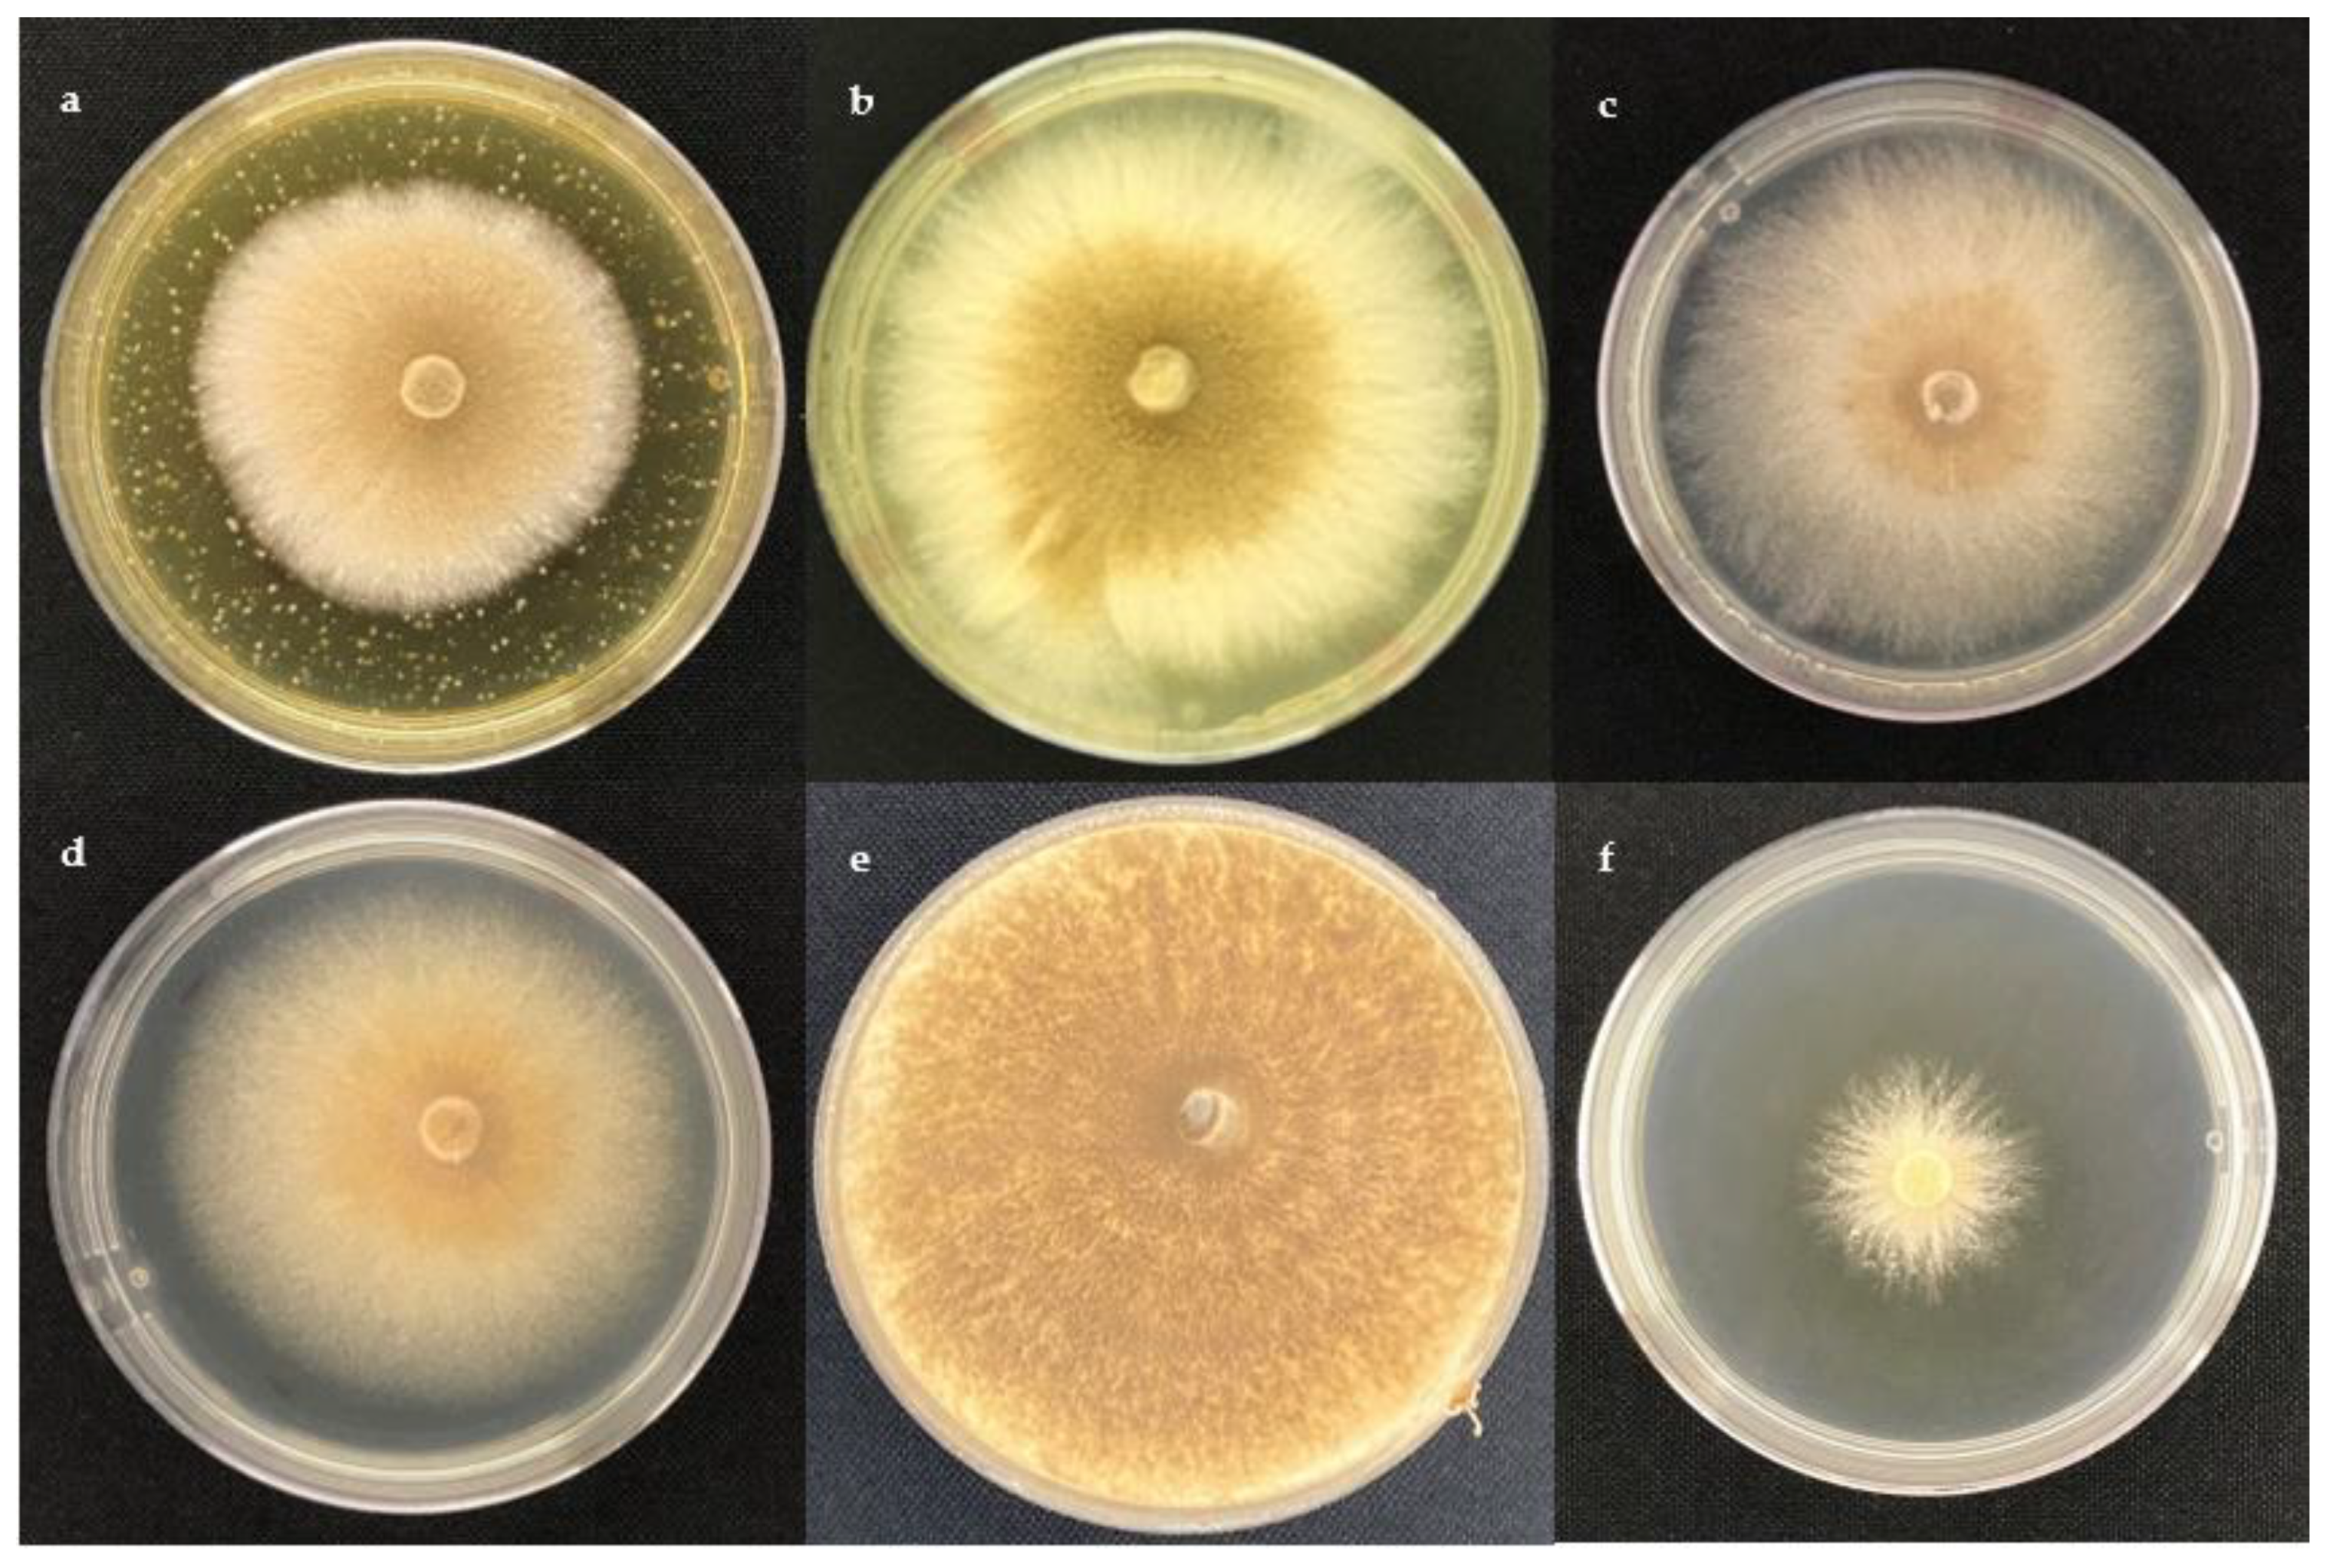
Molecules 28 03208 g002

Chemical Characterization of Trichoderma spp. Extracts with Antifungal Activity against Cocoa Pathogens
Abstract
1. Introduction
2. Results and Discussion
2.1. Antifungal Activity
2.2. Chemical Screening
2.3. GC-MS Metabolite Profile
3. Materials and Methods
3.1. Standards and Chemicals
3.2. Fungal Strains
3.3. Extraction Procedure
3.4. Antifungal Assay
3.5. Chemical Screening
3.6. Gas Chromatography–Mass Spectrometry (GC-MS) Analysis
3.7. Statistical Analysis
4. Conclusions
Author Contributions
Funding
Institutional Review Board Statement
Informed Consent Statement
Data Availability Statement
Acknowledgments
Conflicts of Interest
Sample Availability
References
- Armengot, L.; Ferrari, L.; Milz, J.; Velásquez, F.; Hohmann, P.; Schneider, M. Cacao Agroforestry Systems Do Not Increase Pest and Disease Incidence Compared with Monocultures under Good Cultural Management Practices. Crop. Prot. 2020, 130, 105047. [Google Scholar] [CrossRef]
- International Cocoa Organization (ICCO) Production of Cocoa Beans. Available online: https://www.icco.org/statistics (accessed on 16 February 2023).
- Anzules-Toala, V.; Pazmiño-Bonilla, E.; Alvarado-Huamán, L.; Borjas-Ventura, R.; Castro-Cepero, V.; Julca-Otiniano, A. Control of Cacao (Theobroma cacao) Diseases in Santo Domingo de Los Tsachilas, Ecuador. Agron. Mesoam. 2022, 33, 45939. [Google Scholar] [CrossRef]
- Orea, M.D.D.; Romero-Cortes, T.; Lopez-Perez, P.A.; Perez Espana, V.H.; Ramirez-Lepe, M.; Cuervo-Parra, J.A. Current Status of Cocoa Frosty Pod Rot Caused by Moniliophthora roreri and a Phylogenetic Analysis. Plant Pathol. J. (Faisalabad) 2017, 16, 41–53. [Google Scholar] [CrossRef]
- Meraz-Pérez, I.M.; Carvalho, M.R.; Sena, K.F.; Soares, Y.J.B.; Junior, A.S.E.; Lopes, U.V.; dos Santos Filho, L.P.; Araújo, S.A.; Soares, V.L.F.; Pirovani, C.P.; et al. The Moniliophthora perniciosa—Cacao Pod Pathosystem: Structural and Activated Defense Strategies against Disease Establishment. Physiol. Mol. Plant Pathol. 2021, 115, 101656. [Google Scholar] [CrossRef]
- Maridueña-Zavala, M.G.; Feijoo, M.I.J.; Cevallos-Cevallos, J.M. Pathogenicity of Moniliophthora roreri Isolates from Selected Morphology Groups in Harvested Cacao Pods and in Vitro Sensitivity to Compost Tea. Bionatura 2021, 6, 1569–1574. [Google Scholar] [CrossRef]
- Maridueña-Zavala, M.G.; Villavicencio-Vásquez, M.E.; Cevallos-Cevallos, J.M.; Peralta, E.L. Molecular and Morphological Characterization of Moniliophthora roreri Isolates from Cacao in Ecuador. Can. J. Plant Pathol. 2016, 38, 460–469. [Google Scholar] [CrossRef]
- Maridueña-Zavala, M.G.; Freire-Peñaherrera, A.; Espinoza-Lozano, R.F.; Villavicencio-Vasquez, M.; Jimenez-Feijoo, M.; Cevallos-Cevallos, J.M. Genetic Characterization of Moniliophthora perniciosa from Ecuador and in Vitro Sensitivity to Compost Tea. Eur. J. Plant Pathol. 2019, 154, 943–959. [Google Scholar] [CrossRef]
- Espinoza-Lozano, F.; Amaya-Márquez, D.; Pinto, C.M.; Villavicencio-Vásquez, M.; Sosa Del Castillo, D.; Pérez-Martínez, S. Multiple Introductions of Moniliophthora roreri from the Amazon to the Pacific Region in Ecuador and Shared High Azoxystrobin Sensitivity. Agronomy 2022, 12, 1119. [Google Scholar] [CrossRef]
- ten Hoopen, G.M.; Krauss, U. Biological Control of Cacao Diseases. In Cacao Diseases: A History of Old Enemies and New Encounters; Bailey, B.A., Meinhardt, L.W., Eds.; Springer International Publishing: Cham, Switzerland, 2016; pp. 511–566. [Google Scholar]
- di Cologna, N.M.D.; Gómez-Mendoza, D.P.; Zanoelo, F.F.; Giannesi, G.C.; Guimarães, N.C.A.; Moreira, L.R.S.; Filho, E.X.F.; Ricart, C.A.O. Exploring Trichoderma and Aspergillus Secretomes: Proteomics Approaches for the Identification of Enzymes of Biotechnological Interest. Enzym. Microb Technol. 2018, 109, 1–10. [Google Scholar] [CrossRef]
- Adnan, M.; Islam, W.; Shabbir, A.; Khan, K.A.; Ghramh, H.A.; Huang, Z.; Chen, H.Y.H.; Lu, G. Plant Defense against Fungal Pathogens by Antagonistic Fungi with Trichoderma in Focus. Microb. Pathog. 2019, 129, 7–18. [Google Scholar] [CrossRef] [PubMed]
- Ferreira, F.V.; Musumeci, M.A. Trichoderma as Biological Control Agent: Scope and Prospects to Improve Efficacy. World J. Microbiol. Biotechnol. 2021, 37, 90. [Google Scholar] [CrossRef]
- Vinale, F.; Strakowska, J.; Mazzei, P.; Piccolo, A.; Marra, R.; Lombardi, N.; Manganiello, G.; Pascale, A.; Woo, S.L.; Lorito, M. Cremenolide, a New Antifungal, 10-Member Lactone from Trichoderma Cremeum with Plant Growth Promotion Activity. Nat. Prod. Res. 2016, 30, 2575–2581. [Google Scholar] [CrossRef] [PubMed]
- Guzmán-Guzmán, P.; Kumar, A.; Santos-Villalobos, S.D.L.; Parra-Cota, F.I.; Orozco-Mosqueda, M.D.C.; Fadiji, A.E.; Hyder, S.; Babalola, O.O.; Santoyo, G. Trichoderma Species: Our Best Fungal Allies in the Biocontrol of Plant Diseases—A Review. Plants 2023, 12, 432. [Google Scholar] [CrossRef] [PubMed]
- Salwan, R.; Sharma, A.; Kaur, R.; Sharma, R.; Sharma, V. The Riddles of Trichoderma Induced Plant Immunity. Biol. Control 2022, 174, 105037. [Google Scholar] [CrossRef]
- Verma, M.; Brar, S.K.; Tyagi, R.D.; Surampalli, R.Y.; Valéro, J.R. Antagonistic Fungi, Trichoderma Spp.: Panoply of Biological Control. Biochem. Eng. J. 2007, 37, 1–20. [Google Scholar] [CrossRef]
- Ahluwalia, V.; Kumar, J.; Rana, V.S.; Sati, O.P.; Walia, S. Comparative Evaluation of Two Trichoderma harzianum Strains for Major Secondary Metabolite Production and Antifungal Activity. Nat. Prod. Res. 2015, 29, 914–920. [Google Scholar] [CrossRef]
- Rukachaisirikul, V.; Chinpha, S.; Phongpaichit, S.; Saikhwan, N.; Sakayaroj, J.; Preedanon, S. Sesquiterpene and Monoterpene Derivatives from the Soil-Derived Fungus Trichoderma reesei PSU-SPSF013. Phytochem. Lett. 2019, 30, 124–129. [Google Scholar] [CrossRef]
- Dashtban, M.; Kepka, G.; Seiboth, B.; Qin, W. Xylitol Production by Genetically Engineered Trichoderma reesei Strains Using Barley Straw as Feedstock. Appl. Biochem. Biotechnol. 2013, 169, 554–569. [Google Scholar] [CrossRef]
- Reyes-Figueroa, O.; Ortiz-García, C.F.; Torres-de la Cruz, M.; Lagunes-Espinoza, L.D.; Valdovinos-Ponce, G. Trichoderma Del Agroecosistema Cacao Con Potencial de Biocontrol Sobre Moniliophthora roreri. Rev. Chapingo Ser. Cienc. For. Ambiente 2016, 22, 149–163. [Google Scholar] [CrossRef]
- Mejia, L.; Rojas, E.I.; Maynard, Z.; Van Bael, S.; Arnold, A.E.; Hebbar, P.; Samuels, G.J.; Robbins, N.; Herre, E.A. Endophytic Fungi as Biocontrol Agents of Theobroma cacao Pathogens. Biol. Control 2008, 46, 4–14. [Google Scholar] [CrossRef]
- Krauss, U.; Soberanis, W. Effect of Fertilization and Biocontrol Application Frequency on Cocoa Pod Diseases. Biol. Control 2002, 24, 82–89. [Google Scholar] [CrossRef]
- Leiva, S.; Oliva, M.; Hernández, E.; Chuquibala, B.; Rubio, K.; García, F.; de la Cruz, M.T. Assessment of the Potential of Trichoderma Spp. Strains Native to Bagua (Amazonas, Peru) in the Biocontrol of Frosty Pod Rot (Moniliophthora roreri). Agronomy 2020, 10, 1376. [Google Scholar] [CrossRef]
- Bastos, C.N. Isolate of Trichoderma Brevicompactum for the Control of Cocoa Witches Broom Disease: Preliminary Results. Agrotrópica 2012, 24, 21–26. [Google Scholar] [CrossRef]
- Gonzalez, M.F.; Magdama, F.; Galarza, L.; Sosa, D.; Romero, C. Evaluation of the Sensitivity and Synergistic Effect of Trichoderma reesei and Mancozeb to Inhibit under In Vitro Conditions the Growth of Fusarium oxysporum. Commun. Integr. Biol. 2020, 13, 160–169. [Google Scholar] [CrossRef] [PubMed]
- Galarza, L.; Akagi, Y.; Takao, K.; Kim, C.S.; Maekawa, N.; Itai, A.; Peralta, E.; Santos, E.; Kodama, M. Characterization of Trichoderma Species Isolated in Ecuador and Their Antagonistic Activities against Phytopathogenic Fungi from Ecuador and Japan. J. Gen. Plant Pathol. 2015, 81, 201–210. [Google Scholar] [CrossRef]
- Aneja, M.; Gianfagna, T.J.; Hebbar, P.K. Trichoderma harzianum Produces Nonanoic Acid, an Inhibitor of Spore Germination and Mycelial Growth of Two Cacao Pathogens. Physiol. Mol. Plant Pathol. 2005, 67, 304–307. [Google Scholar] [CrossRef]
- Evans, H.C.; Holmes, K.A.; Thomas, S.E. Endophytes and Mycoparasites Associated with an Indigenous Forest Tree, Theobroma Gileri, in Ecuador and a Preliminary Assessment of Their Potential as Biocontrol Agents of Cocoa Diseases. Mycol. Prog. 2003, 2, 149–160. [Google Scholar] [CrossRef]
- Villavicencio-Vásquez, M.; Espinoza-Lozano, R.F.; Pérez-Martínez, S.; Sosa, D.; Castillo, D. Hongos Endófitos Foliares Como Candidatos a Biocontroladores Contra Moniliophthora Spp. de Theobroma cacao (Malvaceae) En Ecuador. Acta Biol. Colomb. 2018, 23, 235–241. [Google Scholar] [CrossRef]
- Serrano, L.; Sosa Moreno, A.; Sosa Del Castillo, D.; Bonilla, J.; Romero, C.A.; Galarza, L.L.; Coronel–león, J.R. Biosurfactants Synthesized by Endophytic Bacillus Strains as Control of Moniliophthora perniciosa and Moniliophthora roreri. Sci. Agric. 2021, 78, e20200172. [Google Scholar] [CrossRef]
- Vargas Inciarte, L.; Fuenmayor Arrieta, Y.; Luzardo Méndez, M.; da Costa Jardin, M.; Vera, A.; Carmona, D.; Homen Pereira, M.; da Costa Jardin, P.; San Blas, E. Use of Different Trichoderma Species in Cherry Type Tomatoes (Solanum lycopersicun L.) Against Fusarium oxysporum Wilt in Tropical Greenhouses. Agron. Costarric. 2019, 43, 85–100. [Google Scholar] [CrossRef]
- Villavicencio, M.; Schuller, L.; Espinosa, F.; Noceda, C.; Sosa, D.; Pérez-Martínez, S. Foliar Endophytic Fungi of Theobroma cacao Stimulate More than Inhibit Moniliophthora Spp. Growth and Behave More as an Endophytes than Pathogens. AgriRxiv 2020, 2020, 1–33. [Google Scholar] [CrossRef]
- Moïse, N.A.; Severin, T.N.; Christelle, S.E.; Tibo, A.A.; Lambert, S.M.; Duplex, W.J. Efficacy of Trichoderma harzianum (Edtm) and Trichoderma Aureoviride (T4) as Potential Bio-Control Agent of Taro Leaf Blight Caused by Phytophthora Colocasiae. Int. J. Appl. Microbiol. Biotechnol. Res. 2018, 6, 115–126. [Google Scholar]
- Hu, Z.; Tao, Y.; Tao, X.; Su, Q.; Cai, J.; Qin, C.; Ding, W.; Li, C. Sesquiterpenes with Phytopathogenic Fungi Inhibitory Activities from Fungus Trichoderma Virens from Litchi Chinensis Sonn. J. Agric. Food Chem. 2019, 67, 10646–10652. [Google Scholar] [CrossRef] [PubMed]
- De Carvalho, R.B.F.; De Almeida, A.A.C.; Campelo, N.B.; Lellis, D.R.O.D.; Nunes, L.C.C. Nerolidol and Its Pharmacological Application in Treating Neurodegenerative Diseases: A Review. Recent Pat. Biotechnol. 2018, 12, 158–168. [Google Scholar] [CrossRef]
- Afoulous, S.; Ferhout, H.; Raoelison, E.G.; Valentin, A.; Moukarzel, B.; Couderc, F.; Bouajila, J. Chemical Composition and Anticancer, Antiinflammatory, Antioxidant and Antimalarial Activities of Leaves Essential Oil of Cedrelopsis Grevei. Food Chem. Toxicol. 2013, 56, 352–362. [Google Scholar] [CrossRef] [PubMed]
- Nuñez, Y.O.; Salabarria, I.S.; Collado, I.G.; Hernández-Galán, R. The Antifungal Activity of Widdrol and Its Biotransformation by Colletotrichum gloeosporioides (Penz.) Penz. & Sacc. and Botrytis cinerea Pers.: Fr. J. Agric. Food Chem. 2006, 54, 7517–7521. [Google Scholar] [CrossRef] [PubMed]
- Lee, S.; Yap, M.; Behringer, G.; Hung, R.; Bennett, J.W. Volatile Organic Compounds Emitted by Trichoderma Species Mediate Plant Growth. Fungal Biol. Biotechnol. 2016, 3, 7. [Google Scholar] [CrossRef]
- Dahham, S.; Tabana, Y.; Iqbal, M.; Ahamed, M.; Ezzat, M.; Majid, A.; Majid, A. The Anticancer, Antioxidant and Antimicrobial Properties of the Sesquiterpene β-Caryophyllene from the Essential Oil of Aquilaria Crassna. Molecules 2015, 20, 11808–11829. [Google Scholar] [CrossRef]
- Morath, S.U.; Hung, R.; Bennett, J.W. Fungal Volatile Organic Compounds: A Review with Emphasis on Their Biotechnological Potential. Fungal Biol. Rev. 2012, 26, 73–83. [Google Scholar] [CrossRef]
- Pinheiro, E.A.A.; Carvalho, J.M.; dos Santos, D.C.P.; Feitosa, A.O.; Marinho, P.S.B.; Guilhon, G.M.S.P.; Santos, L.S.; de Souza, A.L.D.; Marinho, A.M.R.; Pinheiro, E.A.A.; et al. Chemical Constituents of Aspergillus Sp. EJC08 Isolated as Endophyte from Bauhinia Guianensis and Their Antimicrobial Activity. Acad. Bras. Ciências 2013, 85, 1247–1253. [Google Scholar] [CrossRef] [PubMed]
- Meng, J.; Wang, X.; Xu, D.; Fu, X.; Zhang, X.; Lai, D.; Zhou, L.; Zhang, G. Sorbicillinoids from Fungi and Their Bioactivities. Molecules 2016, 21, 715. [Google Scholar] [CrossRef] [PubMed]
- Li, C.; Gu, R.; Lin, F.; Xiao, H. Sorbicillinoids Hyperproduction without Affecting the Cellulosic Enzyme Production in Trichoderma reesei JNTR5. Biotechnol. Biofuels Bioprod. 2022, 15, 85. [Google Scholar] [CrossRef]
- Ngo, M.; Nguyen, M.; Han, J.; Park, M.; Kim, H.; Choi, G. In Vitro and in Vivo Antifungal Activity of Sorbicillinoids Produced by Trichoderma longibrachiatum Men. J. Fungi 2021, 7, 428. [Google Scholar] [CrossRef] [PubMed]
- Kotan, R.; Kordali, S.; Cakir, A. Screening of Antibacterial Activities of Twenty-One Oxygenated Monoterpenes. Z. Nat. C 2007, 62, 507–513. [Google Scholar] [CrossRef]
- Pohl, C.; Kock, J.; Thibane, V. Antifungal Free Fatty Acids: A Review. Sci. Against Microb. Pathog. Commun. Curr. Res. Technol. Adv. 2011, 3, 61–71. [Google Scholar]
- Stracquadanio, C.; Quiles, J.M.; Meca, G.; Cacciola, S.O. Antifungal Activity of Bioactive Metabolites Produced by Trichoderma and Trichoderma in Liquid Medium. J. Fungi 2020, 6, 263. [Google Scholar] [CrossRef]
- Gajera, H.P.; Hirpara, D.G.; Savaliya, D.D.; Golakiya, B.A. Extracellular Metabolomics of Trichoderma Biocontroller for Antifungal Action to Restrain Rhizoctonia solani Kuhn in Cotton. Physiol. Mol. Plant Pathol. 2020, 112, 101547. [Google Scholar] [CrossRef]
- Uranga, C.C.; Beld, J.; Mrse, A.; Córdova-Guerrero, I.; Burkart, M.D.; Hernández-Martínez, R. Fatty Acid Esters Produced by Lasiodiplodia Theobromae Function as Growth Regulators in Tobacco Seedlings. Biochem. Biophys. Res. Commun. 2016, 472, 339–345. [Google Scholar] [CrossRef]
- Gregori, R.; Borsetti, F.; Neri, F.; Mari, M.; Bertolini, P. Effects of Potassium Sorbate on Postharvest Brown Rot of Stone Fruit. J. Food Prot. 2008, 71, 1626–1631. [Google Scholar] [CrossRef]
- Liu, Q.; Ouyang, S.P.; Chung, A.; Wu, Q.; Chen, G.Q. Microbial Production of R-3-Hydroxybutyric Acid by Recombinant E. Coli Harboring Genes of PhbA, PhbB, and TesB. Appl. Microbiol. Biotechnol. 2007, 76, 811–818. [Google Scholar] [CrossRef] [PubMed]
- Marra, R.; Nicoletti, R.; Pagano, E.; DellaGreca, M.; Salvatore, M.M.; Borrelli, F.; Lombardi, N.; Vinale, F.; Woo, S.L.; Andolfi, A. Inhibitory Effect of Trichodermanone C, a Sorbicillinoid Produced by Trichoderma citrinoviride Associated to the Green Alga Cladophora Sp., on Nitrite Production in LPS-Stimulated Macrophages. Nat. Prod. Res. 2019, 33, 3389–3397. [Google Scholar] [CrossRef]
- Wongsuk, T.; Pumeesat, P.; Luplertlop, N. Fungal Quorum Sensing Molecules: Role in Fungal Morphogenesis and Pathogenicity. J. Basic Microbiol. 2016, 56, 440–447. [Google Scholar] [CrossRef]
- Brilhante, R.S.N.; Caetano, P.; de Lima, R.A.C.; Marques, F.J.D.F.; Castelo-Branco, D.D.S.C.M.; de Melo, C.V.S.; Guedes, G.M.D.M.; de Oliveira, J.S.; de Camargo, Z.P.; Moreira, J.L.B.; et al. Terpinen-4-Ol, Tyrosol, and β-Lapachone as Potential Antifungals against Dimorphic Fungi. Braz. J. Microbiol. 2016, 47, 917–924. [Google Scholar] [CrossRef]
- Li, M.F.; Li, G.H.; Zhang, K.Q. Non-Volatile Metabolites from Trichoderma Spp. Metabolites 2019, 9, 58. [Google Scholar] [CrossRef] [PubMed]
- Pelo, S.P.; Adebo, O.A.; Green, E. Chemotaxonomic Profiling of Fungal Endophytes of Solanum Mauritianum (Alien Weed) Using Gas Chromatography High Resolution Time-of-Flight Mass Spectrometry (GC-HRTOF-MS). Metabolomics 2021, 17, 43. [Google Scholar] [CrossRef]
- Al-Marzoqi, A.H.; Hameed, I.H.; Idan, S.A. Analysis of Bioactive Chemical Components of Two Medicinal Plants (Coriandrum Sativum and Melia Azedarach) Leaves Using Gas Chromatography-Mass Spectrometry (GC-MS). Afr. J. Biotechnol. 2015, 14, 2812–2830. [Google Scholar] [CrossRef]
- Walters, D.; Raynor, L.; Mitchell, A.; Walker, R.; Walker, K. Antifungal Activities of Four Fatty Acids against Plant Pathogenic Fungi. Mycopathologia 2004, 157, 87–90. [Google Scholar] [CrossRef] [PubMed]
- Maridueña-Zavala, M.G.; Quevedo, A.; Aguaguiña, K.; Serrano, L.; Sosa, D. Colección de Cultivos Microbianos CIBE (CCM-CIBE): Una Colección Para La Investigación Microbial Culture Collection from CIBE (CCM-CIBE): A Collection for Research. Rev. Bionatura 2021, 6, 1664–1668. [Google Scholar] [CrossRef]
- White, T.J.; Bruns, T.; Lee, S.; Taylor, J. Amplification and Direct Sequencing of Fungal Ribosomal RNA Genes for Phylogenetics. In PCR Protocols: A Guide to Methods and Applications; Innis, M.A., Gelfand, D.H., Sninsky, J.J., White, T.J., Eds.; Academic Press: San Diego, CA, USA, 1990; pp. 315–322. [Google Scholar] [CrossRef]
- Liu, J.; Liu, G. Analysis of Secondary Metabolites from Plant Endophytic Fungi. In Plant Pathogenic Fungi and Oomycetes. Methods in Molecular Biology; Ma, W., Wolpert, T., Eds.; Humana Press: New York, NY, USA, 2018; Volume 1848, pp. 25–38. [Google Scholar]
- Kjer, J.; Debbab, A.; Aly, A.H.; Proksch, P. Methods for Isolation of Marine-Derived Endophytic Fungi and Their Bioactive Secondary Products. Nat. Protoc. 2010, 5, 479–490. [Google Scholar] [CrossRef]
- Guerrero-Rodríguez, E.; Solís-Gaona, S.; Hernández-Castillo, F.D.; Flores-Olivas, A.; Sandoval-López, V.; Jasso-Cantú, V. Actividad Biológica in Vitro de Extractos de Flourensia cernua D.C. en Patógenos de Postcosecha: Alternaria alternata (Fr.:Fr.) Keissl., Colletotrichum gloeosporioides (Penz.) Penz. y Sacc. y Penicillium digitatum (Pers.:Fr.) Sacc. Rev. Mex. Fitopatol. 2007, 25, 48–53. [Google Scholar]
- Jakšić, D.; Kocsubé, S.; Bencsik, O.; Kecskeméti, A.; Szekeres, A.; Jelić, D.; Kopjar, N.; Vágvölgyi, C.; Varga, J.; Šegvić Klarić, M. Fumonisin Production and Toxic Capacity in Airborne Black Aspergilli. Toxicol. Vitr. 2018, 53, 160–171. [Google Scholar] [CrossRef] [PubMed]
- Ezziyyani, M.; Pérez Sánchez, C.; Emilia Requena, M.; Rubio, L.; Emilia Candela, M.; Candela, C.M.E. Biocontrol Por Streptomyces Rochei-Ziyani-, de La Podredumbre Del Pimiento (Capsicum annuum L.) Causada Por Phytophthora Capsici. An. Biol. 2004, 26, 69–78. [Google Scholar]
- Tiwari, P.; Kumar, B.; Kaur, M.; Kaur, G.; Kaur, H. Phytochemical Screening and Extraction: A Review. Int. Pharm. Sci. 2011, 1, 98–106. [Google Scholar]
- Arispe Vazquez, J.L.; Sanchez Arizpe, A.; Galindo Cepeda, M.E.; Vazquez Badillo, M.E.; Oyervides Garcia, A.; Rodriguez Guerra, R. Antagonism of Trichoderma Spp. in Fungi Associated with Damage of Diatraea saccharalis Fabricius. (Lepidoptera: Crambidae) in Corn. Boletín Micológico 2019, 34, 17–24. [Google Scholar] [CrossRef]

| Secondary Metabolites | Test | C2A | C3A | C4A | C10 |
|---|---|---|---|---|---|
| Alkaloids | Dragendorff | – | – | + | – |
| Mayer | ++ | – | – | – | |
| Wagner | +++ | – | – | – | |
| Lactones | Baljet | ++ | ++ | ++ | ++ |
| Quinones | Borntrager | ++ | – | – | +++ |
| Triterpenes and sterols | Liebermann-Burchard | + | + | + | + |
| Resins | Resins | – | – | – | – |
| Reducing sugars | Fehling | +++ | +++ | +++ | +++ |
| Saponins | Foam | – | – | – | – |
| Amino acids | Ninhydrin | – | – | – | – |
| Flavonoids | Shinoda | – | – | – | + |
| Anthocyanidins | – | – | – | + | |
| Catechins | + | + | – | + |
| Peak | Compounds | Peak Area (%) (1),(2) | Retention Index (Estimated) (3) | Retention Index (Reference) (4) | |||
|---|---|---|---|---|---|---|---|
| C2A | C3A | C4A | C10 | ||||
| 1 | Ethyl Valerate | 0.54 ± 0.06 | 0.95 ± 0.02 | - | - | 901.23 | 884 |
| 2 | 3-Methylcyclohexanol | 0.80 ± 0.19 | - | - | - | 912.21 | 969 |
| 3 | Butyl Isobutyrate | - | 1.22 ± 0.04 | 0.76 ± 0.04 | 1.37 ± 0.01 | 912.66 | 920 |
| 4 | Ethyl 3-Hydroxybutyrate | 1.22 ± 0.11 | - | - | - | 931.88 | 947 |
| 5 | 3-Hydroxybutyric acid | - | - | - | 2.84 ± 0.48 | 942.31 | 938 |
| 6 | 1,1-Diethoxyacetone | 0.05 ± 0.01 | - | - | - | 996.06 | 941 |
| 7 | 4-sec-Butoxy-2-butanone | - | - | 0.07 ± 0.01 | - | 1018.54 | 964 |
| 8 | Sorbic Acid | - | - | - | 0.20 ± 0.02 | 1052.53 | 990 |
| 9 | Phenylethyl Alcohol | 8.90 ± 1.06 | 5.42 ± 0.08 | 3.12 ± 0.13 | 0.83 ± 0.01 | 1104.39 | 1136 |
| 10 | 5,8-Decadien-2-one,5,9-dimethyl-,(E) | - | - | 0.07 ± 0.01 | - | 1125.63 | 1204 |
| 11 | 4-Ethoxy-4-oxobutanoic Acid | 0.13 ± 0.03 | - | - | - | 1154.13 | 1141 |
| 12 | Diethyl Succinate | 0.11 ± 0.01 | 0.19 ± 0.04 | 0.11 ± 0.03 | 0.33 ± 0.00 | 1167.54 | 1151 |
| 13 | β-Fenchyl Alcohol | - | - | 0.69 ± 0.02 | - | 1186.38 | 1138 |
| 14 | 5-Hydroxy-4,4,6-trimethyl-7-oxabicyclo [4.1.0]heptan-2-one | - | - | 0.36 ± 0.03 | - | 1200.26 | 1298 |
| 15 | 4-Hydroxy-2,4,5-trimethyl-2,5-cyclohexadien-1-one | - | - | - | 0.58 ± 0.03 | 1235.51 | 1246 |
| 16 | 1,3-Dioxolane-2-ethanethioic acid, 2-methyl- | 0.10 ± 0.03 | - | - | - | 1239.61 | 1224 |
| 17 | Mevalonolactone | 0.14 ± 0.02 | - | - | - | 1247.20 | 1156 |
| 18 | 2,5-Dimethylhydroquinone | 0.04 ± 0.02 | 0.06 ± 0.00 | - | - | 1364.40 | 1348 |
| 19 | Tyrosol | 1.80 ± 0.16 | 1.73 ± 0.02 | 1.34 ± 0.07 | 0.19 ± 0.00 | 1405.59 | 1356 |
| 20 | 1,4-Cadinadiene | 0.41 ± 0.02 | - | - | - | 1415.20 | 1440 |
| 21 | Neoclovene | - | - | 0.13 ± 0.01 | - | 1437.69 | 1416 |
| 22 | Caryophyllene | 0.09 ± 0.01 | - | - | - | 1440.57 | 1494 |
| 23 | 7-Epi-cis-Sesquisabinene hydrate | 0.05 ± 0.02 | - | - | - | 1495.09 | 1523 |
| 24 | Nerolidol | 0.97 ± 0.07 | 0.11 ± 0.01 | - | - | 1547.13 | 1564 |
| 25 | 1-(3,3,6a-Trimethyl-1a,2,3,5,6a,6b-hexahydro-1H-6-oxa-cyclopropa[e]inden-5-yl)-ethanone | - | - | - | 0.25 ± 0.02 | 1573.29 | 1508 |
| 26 | Spiro[4.5]dec-8-en-7-ol, 1,8-dimethyl-4-(1-methylethyl)- | 6.78 ± 0.80 | 1.12 ± 0.07 | 0.22 ± 0.05 | - | 1652.04 | 1630 |
| 27 | Widdrol | 0.55 ± 0.04 | - | - | - | 1664.67 | 1651 |
| 28 | 4-Acoren-3-one | 0.30 ± 0.01 | - | - | - | 1672.24 | 1614 |
| 29 | 7-Phenylheptan-1-ol | - | - | - | 0.21 ± 0.00 | 1679.42 | 1633 |
| 30 | 6-Phenylhexanoic Acid | - | 0.48 ± 0.08 | - | - | 1679.55 | 1647 |
| 31 | N-Methyl-N-[4-(1-pyrrolidinyl)-2-butynyl]-2-aminoacetamide | 0.09 ± 0.02 | - | - | - | 1684.37 | 1770 |
| 32 | Alpha-Bisabolol oxide B | - | 0.32 ± 0.03 | - | - | 1690.13 | 1707 |
| 33 | Formic acid, 3,7,11-trimethyl-1,6,10-dodecatrien-3-yl ester | 0.09 ± 0.04 | - | - | - | 1690.35 | 1752 |
| 34 | 1-(hydroxymethyl)-2,5,5,8a-tetramethyldecahydro-2-naphthalenol | 1.70 ± 0.18 | 1.99 ± 0.02 | - | - | 1726.09 | 1825 |
| 35 | β-Santanol Acetate | 0.06 ± 0.01 | 0.16 ± 0.04 | - | - | 1795.41 | 1791 |
| 36 | 1,1,4,6-Tetramethyl-1a,2,3,4a,5,7,7a,7b-octahydrocyclopropa[e]azulene-4,5,6-triol | 0.07 ± 0.01 | - | - | - | 1805.00 | 1869 |
| 37 | Methyl 5,7-hexadecadiynoate | - | - | 0.32 ± 0.01 | - | 1828.37 | 1913 |
| 38 | Palmitelaidic Acid | - | 0.19 ± 0.03 | 0.53 ± 0.04 | 0.27 ± 0.03 | 1918.46 | 1976 |
| 39 | Artemisinin | 0.21 ± 0.05 | - | - | - | 1918.63 | 1903 |
| 40 | (S)-3-(4-Hydroxybenzyl)piperazine-2,5-dione | 0.06 ± 0.03 | - | - | - | 1932.11 | 2001 |
| 41 | Palmitic Acid | 4.67 ± 0.78 | 4.44 ± 0.04 | 5.93 ± 0.10 | - | 1942.18 | 1968 |
| 42 | 5α-Acetoxymethyl-4a,5,8,8α-tetrahydro-2,4aβ-dimethyl-1,4-naphthalindione | 1.41 ± 0.13 | - | - | - | 1963.71 | 1998 |
| 43 | Ethyl Palmitate | 0.10 ± 0.02 | - | - | - | 1975.09 | 1978 |
| 44 | 2,3-Dehydro-9-hydroxy-β-agarofuran | 0.26 ± 0.03 | - | - | - | 1979.63 | 2076 |
| 45 | Lactaropallidin | 0.36 ± 0.07 | 0.48 ± 0.02 | - | - | 2018.27 | 2003 |
| 46 | Methyl octadeca-6,9-diynoate | - | - | 0.10 ± 0.00 | - | 2039.21 | 2112 |
| 47 | Hanphyllin | - | 0.18 ± 0.01 | - | - | 2044.11 | 2085 |
| 48 | Linoleic acid | 5.00 ± 1.71 | 6.51 ± 0.13 | 13.42 ± 0.15 | 1.70 ± 0.14 | 2109.95 | 2183 |
| 49 | Oleic acid | 9.76 ± 1.80 | 9.63 ± 0.13 | 11.45 ± 0.13 | 7.57 ± 0.38 | 2116.35 | 2175 |
| 50 | Ethyl Linoleate | - | - | - | 0.48 ± 0.20 | 2126.39 | 2193 |
| 51 | Cyclopropanecarboxylic acid, 2,6-di-t-butyl-4-methoxy-phenyl ester | 0.61 ± 0.04 | 1.32 ± 0.05 | - | - | 2134.17 | 2104 |
| 52 | Stearic acid | 1.58 ± 0.36 | - | - | - | 2139.50 | 2167 |
| 53 | Sorbicillin | 1.96 ± 0.08 | 4.14 ± 0.06 | - | - | 2164.42 | 2160 |
| 54 | 3-Ethyl-3-hydroxyandrostan-17-one | - | - | 0.25 ± 0.08 | - | 2171.72 | 2251 |
| 55 | Acetyloxyparthenin | - | - | - | 0.36 ± 0.07 | 2363.24 | 2284 |
| 56 | 6,8-dimethoxy-3-methyl-3-(3′-methylbut-2′-enyl)-1H-quinoline-2,4-dione | - | - | 2.48 ± 0.45 | - | 2456.98 | 2397 |
| 57 | S-[(E)-1,3-Diphenylbut-2-enyl] N,N-dimethylcarbamothioate | 0.92 ± 0.02 | - | - | - | 2525.64 | 2436 |
| 58 | 4a,7a-Epoxy-5H-cyclopenta[a]cyclopropa[f]cycloundecen-4(1H)-one, 1a,6,7,10,11,11a-hexahydro-7,10,11-trihydroxy-1,1,3,6,9-pentamethyl- | 0.05 ± 0.01 | 0.23 ± 0.02 | - | - | 2534.54 | 2591 |
| 59 | 1,3,5,7,9,11,13,15,17,19,21,23-Cyclotetracosadodecaene | 0.16 ± 0.02 | - | - | - | 2619.26 | 2664 |
| 60 | Phorbol | - | - | 0.40 ± 0.06 | - | 2793.65 | 2774 |
| 61 | 8,9-Benzodispiro[2.0.2.4]decane, 7-(3-methoxy-2-oxa-1-oxocyclopent-5-yl)-10-phenyl- | - | - | - | 0.61 ± 0.02 | 2952.57 | 2974 |
| 62 | 3-Hydroxyspirost-8-en-11-one | - | - | 0.11 ± 0.04 | - | 3130.95 | 3044 |
| 63 | 7,8-Epoxylanostan-11-ol, 3-acetoxy- | 0.10 ± 0.01 | - | - | - | 3139.42 | 3145 |
| Strain | Source | Location | DNA Region | Identity | Identify Code |
|---|---|---|---|---|---|
| C2A | Soil | Guayas, Ecuador | ITS1-5,8-ITS2 | Trichoderma reesei | CCMCIBE-H1103 |
| C3A | Soil | Guayas, Ecuador | ITS1-5,8-ITS2 | Trichoderma sp. | CCMCIBE-H1104 |
| C4A | Soil | Guayas, Ecuador | ITS1-5,8-ITS2 | Trichoderma harzianum | CCMCIBE-H1105 |
| C10 | Soil | Guayas, Ecuador | ITS1-5,8-ITS2 | Trichoderma spirale | CCMCIBE-H1106 |
Disclaimer/Publisher’s Note: The statements, opinions and data contained in all publications are solely those of the individual author(s) and contributor(s) and not of MDPI and/or the editor(s). MDPI and/or the editor(s) disclaim responsibility for any injury to people or property resulting from any ideas, methods, instructions or products referred to in the content. |
© 2023 by the authors. Licensee MDPI, Basel, Switzerland. This article is an open access article distributed under the terms and conditions of the Creative Commons Attribution (CC BY) license (https://creativecommons.org/licenses/by/4.0/).
Share and Cite
Chóez-Guaranda, I.; Espinoza-Lozano, F.; Reyes-Araujo, D.; Romero, C.; Manzano, P.; Galarza, L.; Sosa, D. Chemical Characterization of Trichoderma spp. Extracts with Antifungal Activity against Cocoa Pathogens. Molecules 2023, 28, 3208. https://doi.org/10.3390/molecules28073208
Chóez-Guaranda I, Espinoza-Lozano F, Reyes-Araujo D, Romero C, Manzano P, Galarza L, Sosa D. Chemical Characterization of Trichoderma spp. Extracts with Antifungal Activity against Cocoa Pathogens. Molecules. 2023; 28(7):3208. https://doi.org/10.3390/molecules28073208
Chicago/Turabian StyleChóez-Guaranda, Ivan, Fernando Espinoza-Lozano, Dennys Reyes-Araujo, Christian Romero, Patricia Manzano, Luis Galarza, and Daynet Sosa. 2023. "Chemical Characterization of Trichoderma spp. Extracts with Antifungal Activity against Cocoa Pathogens" Molecules 28, no. 7: 3208. https://doi.org/10.3390/molecules28073208
APA StyleChóez-Guaranda, I., Espinoza-Lozano, F., Reyes-Araujo, D., Romero, C., Manzano, P., Galarza, L., & Sosa, D. (2023). Chemical Characterization of Trichoderma spp. Extracts with Antifungal Activity against Cocoa Pathogens. Molecules, 28(7), 3208. https://doi.org/10.3390/molecules28073208

